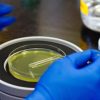

(د ب أ)-قال رئيس البرلمان الألماني نوربرت لامرت إن جميع وثائق البرلمان الألماني بما في ذلك جميع مطبوعاته و محاضر جلساته منذ عام 1949 أصبحت متاحة بشكل كامل على الإنترنت.
وأكد لامرت أن هذه الخطوة توثق تاريخ البرلمان بشكل كامل.
جاء ذلك لدى الإعلان عن عرض النظام الأرشيفي الجديد للبرلمان يوم الأربعاء (27 فبراير 2013) في برلين.
وكان من الممكن حتى الآن البحث إلكترونيا في الوثائق البرلمانية بدءا من الدورة الانتخابية الثامنة قبل أن يتم توفير وثائق الفترة بين عامي 1949 و 1976 بالشكل الرقمي.
وتبلغ صفحات هذه الوثائق نحو 2ر1 مليون صفحة.